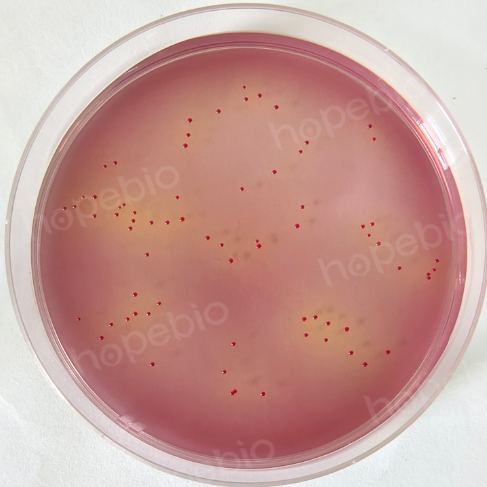

海博微信公众号
海博微信公众号
 海博天猫旗舰店
海博天猫旗舰店


 海博微信公众号
海博微信公众号
 海博天猫旗舰店
海博天猫旗舰店




粪肠球菌作为一种益生菌,在医学和食品工程领域得到广泛应用。另外,肠球菌为消化道内正常存在的一类微生物,在肠黏膜具有较强的耐受和定植能力,并且是一种兼性厌氧的乳酸菌,与厌氧、培养保存条件苛刻的双歧杆菌相比,更适合于生产和应用。
《GB8538-2016 饮用天然矿泉水:粪链球菌检验》
采用滤膜法,将250mL水样用孔径为0.45μm的滤膜过滤,并将滤膜移至KF链球菌琼脂培养基上,于36℃±1℃恒温箱中培养48h,如果有红色或粉红色菌落生长,需将菌落接种于脑-心浸萃琼脂培养基上做进一步的确证试验,如过氧化氢酶反应为阴性,并能在脑-心浸萃琼脂培养基上于45℃培养后生成菌落,则证实粪链球菌的存在,其检测结果为阳性。
粪链球菌检验程序见图1。

图1 粪链球菌检验程序
使用方法:称取本品69.4g,加热溶解于1000mL蒸馏水中,煮沸至完全溶解,冷却至50-60℃时,加入无菌1% TTC溶液10mL,混匀,倾入无菌平皿,备用。
4.1.2 培养:
将培养皿倒置,在36℃±1℃培养48h。
4.1.3 计数:
粪链球菌菌落在滤膜上呈现大小不等的红色或粉红色菌落。挑取不少于5个(不足5个则全挑)可疑菌落,进行革兰氏染色。镜检观察,粪链球菌应为革兰氏染色阳性球菌,常排列成短链状。根据菌落特征符合情况计数每250mL水样中的典型菌落数。
粪链球菌接种到KF链球菌琼脂平板,培养结果如下图所示:
图2 粪链球菌在KF链球菌琼脂平板上的菌落特征
4.2 确证性试验:粪链球菌接种到脑-心浸萃琼脂培养基斜面,培养结果如下图所示:

A:粪链球菌;B:空白对照;
4.2.2 用接种环从脑-心浸萃琼脂培养基斜面上挑取典型培养物到一片清洁的载玻片上,加几滴新鲜配制的3%过氧化氢到载玻片的涂抹菌苔上,如果没有气泡发生,则显示过氧化氢酶反应为阴性,则菌落可视为可疑粪链球菌,需继续如下的确信过程。如果有气泡发生,则过氧化氢酶反应为阳性,因此菌落不属于粪链球菌,确信试验到此即可停止。

A:金黄色葡萄球菌;B:粪链球菌;
粪链球菌接种到脑-心浸萃液态培养基和胆汁液态培养基中,培养结果如下图所示:
图5 粪链球菌在脑-心浸萃液态培养基和胆汁液态培养基中的生长情况
左:脑-心浸萃液态培养基;右:胆汁液态培养基;
A:粪链球菌;B:空白对照;


4.2.4 转移到上述培养基后,若能够生长繁殖,则结果表示为阳性,证实为粪链球菌。
4.3 结果与报告:根据上述典型菌落的计数(4.1.3)和确证性试验为阳性的结果(4.2),计算每250mL水样中的粪链球菌数量,结果以CFU/250mL计。
相关产品:
相关标准:
《GB 8538-2016 饮用天然矿泉水检验方法》 点击下载
注:本文属海博生物原创,未经允许不得转载。
上一篇:乳酸菌检验用培养基及生化反应详解
下一篇:乳酸菌检验的计数方法与规则详解



